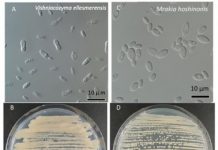
Research: Scientists identify two new species of fungi in retreating Arctic glacier —

Research: Scientists identify two new species of fungi in retreating Arctic glacier —
Two new species of fungi have made an appearance in a rapidly melting glacier on Ellesmere Island in the Canadian Arctic, just west...
Research: Genomic study finds Haida Gwaii’s northern goshawks are highly distinct and at-risk —
Haida Gwaii's small population of northern goshawks -- already of great concern to conservationists -- are the last remnant of a highly distinct...
Research: 3,000-year-old eastern North American quinoa discovered in Ontario —
A mass of charred seeds found while clearing a home construction site in Brantford, Ontario, has been identified as ancient, domesticated goosefoot (C....
Research: Humans have more universal ways of expressing happiness than any other emotion, study...
Human beings can configure their faces in thousands and thousands of ways to convey emotion, but only 35 expressions actually get the job...
Research: Central Texas salamanders, including newly identified species, at risk of extinction —
Biologists at The University of Texas at Austin have discovered three new species of groundwater salamander in Central Texas, including one living west...
Research: Honey bee parasites, varroa mites, feed on fatty organs, not blood —
Honey bee colonies around the world are at risk from a variety of threats, including pesticides, diseases, poor nutrition and habitat loss. Recent...
Research: Climate change-induced melting will raise global sea levels for decades to come —
Antarctica experienced a sixfold increase in yearly ice mass loss between 1979 and 2017, according to a study published today in Proceedings of...
Research: Gut microbes from healthy infants block milk allergy development in mice —
New research suggests that the gut microbiome may help prevent the development of cow's milk allergy. Scientists at the University of Chicago found...
Research: These ‘giant monsters’ were observed suddenly devouring gas in their surroundings —
Supermassive black holes weigh millions to billions times more than our sun and lie at the center of most galaxies. A supermassive black...
Research: Double star system flips planet-forming disk into pole position —
New research led by an astronomer at the University of Warwick has found the first confirmed example of a double star system that...
Top News
Hey ISIS, You Suck: Local Muslims Post Anti-ISIS Billboard
A new billboard on Manchester Road in Missouri reads, "HEY ISIS, YOU SUCK!!! From: #ActualMuslims."
A group of Muslim-Americans have put up a blunt billboard...